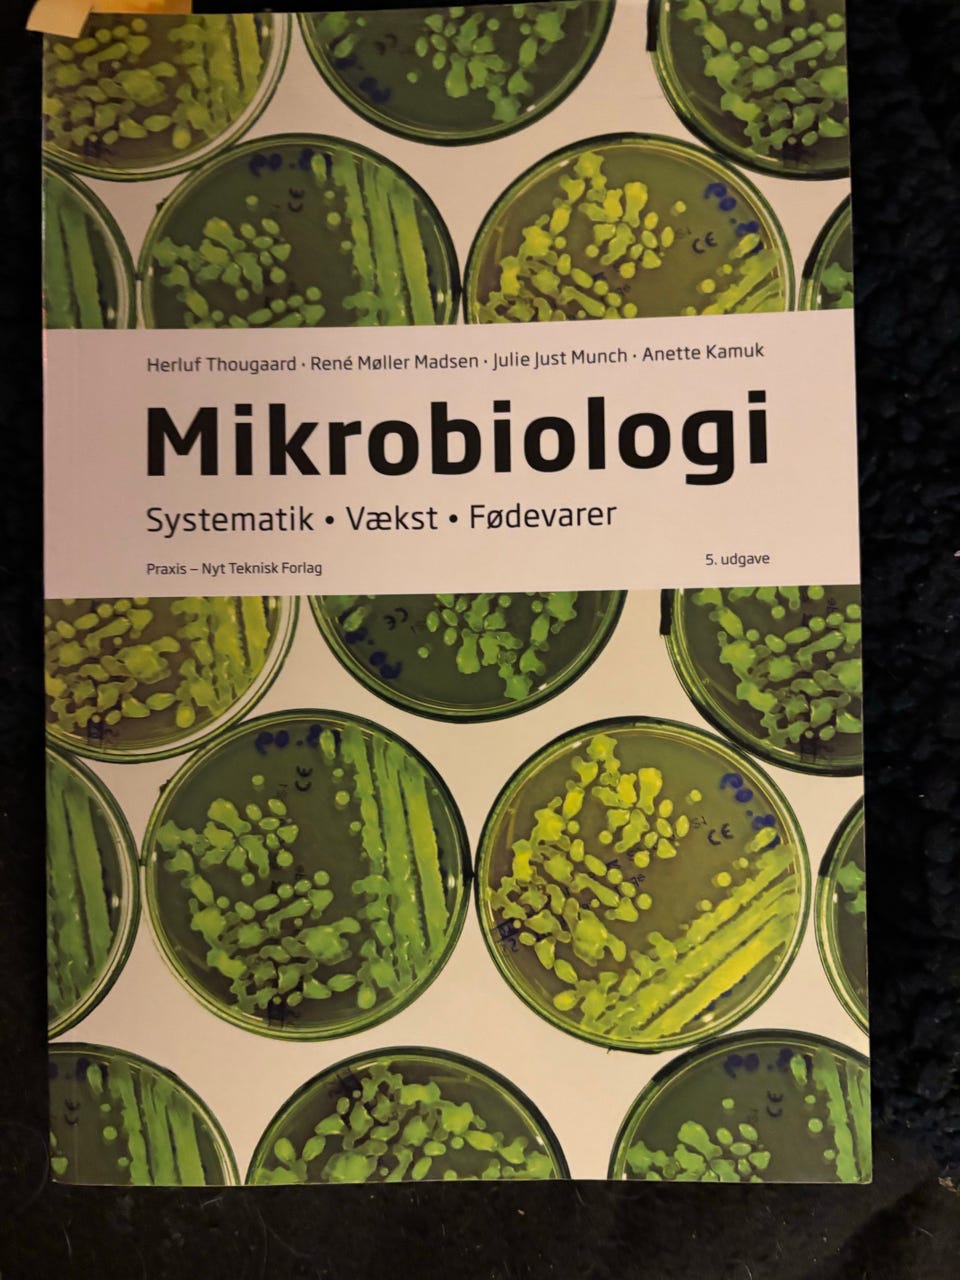
Galleribillede

Billedgalleri
(1/8)
Ernæringsekspert og ernærings teknologi
Til salg
150 kr.
Bed sælgeren om at sende med Fiks færdig! Det er trygt, hurtigt, og varen vil blive sendt til dig. Læs mere
Varebeskrivelse
Stand: Som ny - ingen synlige brugsspor
Emne: Medicin og sundhed
Sæt bestående af lærebøger inden for medicin og sundhed med fokus på ernæring, fødevarer og konserveringsteknik. Bøgerne dækker emner som menneskets ernæring, fødevarer og kvalitet, konserveringsteknik, ernæringsfysiologi samt raffinerede levnedsmidler. Materialet inkluderer grundbøger og faglitteratur med relevant information til studerende eller fagpersoner inden for medicin og sundhed.
Prisen er pr styk
Bemærk: Knappen til at vise den fulde beskrivelse har kun en visuel effekt.
Brugerprofil

Du skal være logget ind for at se brugerprofiler og sende beskeder.
Log indAnnoncens metadata
Sidst redigeret: 20.11.2025 kl. 18:50 ・ Annonce-ID: 16127842